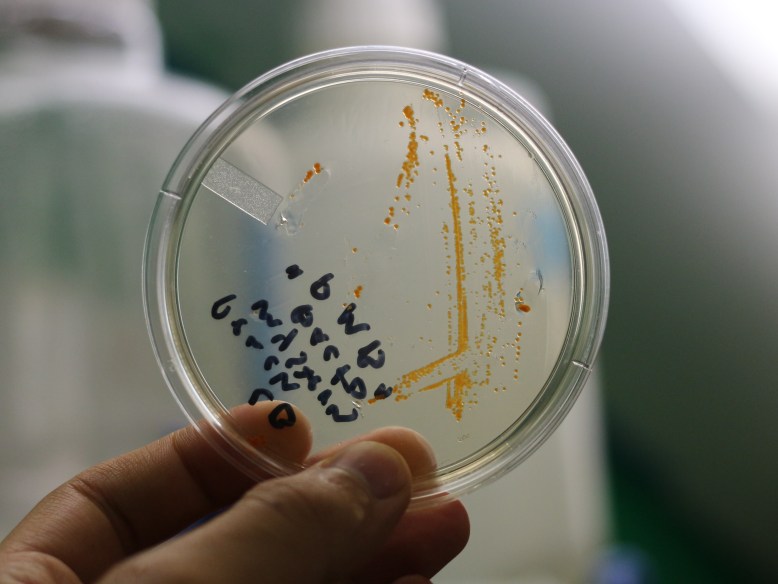
Orange Mystery Bacteria

One of the scientists at BOSSLAB found a bright orange bacterial contaminant in his yeast samples. Since I am interested in pigments and colors, I though it would be fun (since it was already growing in the lab) to sequence the 16s ribosomal DNA to try to identify the species. I have a few notes on the protocol, troubleshooting, and what you should see if you try it.
Materials For Reaction:
- Taq master mix with standard buffer (NEB: M0482S or OpenTaq)
- 8F and 1492R primers (ODIN: 16s primer set)
- PCR water (DNA and DNAse free)
Really any DNA polymerase will work, but I used the NEB 2x OneTaq mastermix.
PCR Settings:
- Heated lid ON
- 10 min Denaturing at 98C
35X cycles of:
- 95 C for 30s
- 55 C for 60s
- 68 C for 3 min
1x final extension at 68 C for 10 min, hold at 4C.
Troubleshooting:
I ran my first attempt at this protocol with a shorter 1 minute extension. This was bad- the region of interest here is ~1.5kb, so at 1kb/min for your typical Taq polymerase, we would require at least 1.5 minutes. I doubled that since I had plenty of time. As you can see in this gel, the shorter extension time meant that I got some pretty small fragments, of varying sizes. They migrated near the dye, which is at about 300bp.
With an extension of the extension time from 1 minute to 3 minutes, you can see that my bands are now sharp, and the right size- about 1.5 kb!
Mystery Resolved! The bacteria is closely related to Sphingomonas aquatilis! You can read about it on microbe wiki. It is pretty cool, and is known to break down a lot of tricky carbon compounds, particularly ones that people consider pollutants. It is also vividly yellow/orange, from its carotenoid pigments.
For your BLAST-ing pleasure, I have included the sequencing data below. These were generated using the 8F and 1492R primers.
>16S-SAMPLE1-8F
GTCGCCTGCCTCTCTTGCGAGTTAGCGCAACGCCTTCGGGTGAACCCAAC
TCCCATGGTGTGACGGGCGGTGTGTACAAGGCCTGGGAACGTATTCACCG
CGGCATGCTGATCCGCGATTACTAGCGATTCCGCCTTCATGCTCTCGAGT
TGCAGAGAACAATCCGAACTGAGACGGCTTTTGGAGATTAGCGCACTCTC
GCGAGTTTGCTGCCCACTGTCACCGCCATTGTAGCACGTGTGTAGCCCAG
CGCGTAAGGGCCATGAGGACTTGACGTCATCCCCACCTTCCTCCGGCTTA
TCACCGGCGGTTCCTTTAGAGTCCCCAACTAAATGATGGTAACTAAAGGC
GAGGGTTGCGCTCGTTGCGGGACTTAACCCAACATCTCACGACACGAGCT
GACGACAGCCATGCAGCACCTGTGTTCCAGTCCCCGAAGGGAAGGAGTCC
ATCTCTGGAAACCGTCCGGACATGTCAAACGCTGGTAAGGTTCTGCGCGT
TGCTTCGAATTAAACCACATGCTCCACCGCTTGTGCAGGCCCCCGTCAAT
TCATTTGAGTTTTAACCTTGCGGCCGTACTCCCCAGGCGGATAACTTAAT
GCGTTAGCTGCGCCACCCAAAGACCAAGTCCCCGGACAGCTAGTTATCAT
CGTTTACGGCGTGGACTACCAGGGTATCTAATCCTGTTTGCTCCCCACGC
TTTCGCACCTCAGCGTCAATACCAGTCCAGTGAGCCGCCTTCGCCACTGG
TGTTCTTCCGAATATCTACGAATTTCACCTCTACACTCGGAATTCCACTC
ACCTCTCCTGGATTCAAGCGATGCAGTCTTAAAGGCAATTCTGGAGTTGA
GCTCCAGGCTTTCACCTCTAACTTACAAAGCCGCCTACGTGCGCTT
>16S-SAMPLE1-1492R
CTTCGGATCTAGTGGCGCACGGGTGCGTAACGCGTGGGAATCTGCCCTTT
GGTTCGGAATAACAGTTGGAAACGACTGCTAATACCGGATGATGACGTAA
GTCCAAAGATTTATCGCCAGAGGATGAGCCCGCGTAGGATTAGCTAGTTG
GTGTGGTAAGAGCGCACCAAGGCGACGATCCTTAGCTGGTCTGAGAGGAT
GATCAGCCACACTGGGACTGAGACACGGCCCAGACTCCTACGGGAGGCAG
CAGTGGGGAATATTGGACAATGGGCGAAAGCCTGATCCAGCAATGCCGCG
TGAGTGATGAAGGCCTTAGGGTTGTAAAGCTCTTTTACCCGGGATGATAA
TGACAGTACCGGGAGAATAAGCTCCGGCTAACTCCGTGCCAGCAGCCGCG
GTAATACGGAGGGAGCTAGCGTTGTTCGGAATTACTGGGCGTAAAGCGCA
CGTAGGCGGCTTTGTAAGTTAGAGGTGAAAGCCTGGAGCTCAACTCCAGA
ATTGCCTTTAAGACTGCATCGCTTGAATCCAGGAGAGGTGAGTGGAATTC
CGAGTGTAGAGGTGAAATTCGTAGATATTCGGAAGAACACCAGTGGCGAA
GGCGGCTCACTGGACTGGTATTGACGCTGAGGTGCGAAAGCGTGGGGAGC
AAACAGGATTAGATACCCTGGTAGTCCACGCCGTAAACGATGATAACTAG
CTGTCCGGGGACTTGGTCTTTGGGTG